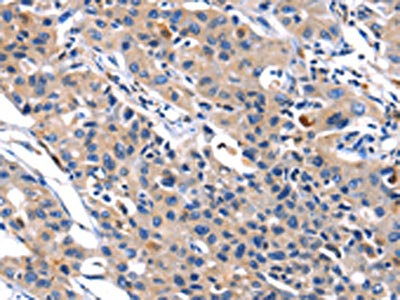

MMP16 Antibody
-
中文名稱:MMP16兔多克隆抗體
-
貨號:CSB-PA598539
-
規(guī)格:¥1100
-
圖片:
-
其他:
產(chǎn)品詳情
-
Uniprot No.:
-
基因名:MMP16
-
別名:MMP16; C8orf57; MMPX2; Matrix metalloproteinase-16; MMP-16; MMP-X2; Membrane-type matrix metalloproteinase 3; MT-MMP 3; MTMMP3; Membrane-type-3 matrix metalloproteinase; MT3-MMP; MT3MMP
-
宿主:Rabbit
-
反應(yīng)種屬:Human,Mouse,Rat
-
免疫原:Fusion protein of Human MMP16
-
免疫原種屬:Homo sapiens (Human)
-
標(biāo)記方式:Non-conjugated
-
抗體亞型:IgG
-
純化方式:Antigen affinity purification
-
濃度:It differs from different batches. Please contact us to confirm it.
-
保存緩沖液:-20°C, pH7.4 PBS, 0.05% NaN3, 40% Glycerol
-
產(chǎn)品提供形式:Liquid
-
應(yīng)用范圍:ELISA,IHC
-
推薦稀釋比:
Application Recommended Dilution ELISA 1:1000-1:5000 IHC 1:50-1:200 -
Protocols:
-
儲存條件:Upon receipt, store at -20°C or -80°C. Avoid repeated freeze.
-
貨期:Basically, we can dispatch the products out in 1-3 working days after receiving your orders. Delivery time maybe differs from different purchasing way or location, please kindly consult your local distributors for specific delivery time.
-
用途:For Research Use Only. Not for use in diagnostic or therapeutic procedures.
相關(guān)產(chǎn)品
靶點詳情
-
功能:Endopeptidase that degrades various components of the extracellular matrix, such as collagen type III and fibronectin. Activates progelatinase A. Involved in the matrix remodeling of blood vessels. Isoform short cleaves fibronectin and also collagen type III, but at lower rate. It has no effect on type I, II, IV and V collagen. However, upon interaction with CSPG4, it may be involved in degradation and invasion of type I collagen by melanoma cells.
-
基因功能參考文獻(xiàn):
- Overexpression of MMP2 and MMP16 in endometrial cancerous tissues corresponded to down-regulation of miR-377, miR-382 and miR-410, while decreased expression of TIMP2 was associated with miR-200b up-regulation. PMID: 28871006
- MMP16 was highly expressed and correlated with poor prognosis in gastric cancer patients by promoting proliferation and invasion of gastric cancer cells PMID: 27340864
- the present findings indicate that MT3-MMP is down-regulated in ESCC, which correlates to lymph node metastasis and poor survival of patients with this disease. PMID: 27292876
- more severe intervertebral disc degeneration is correlated with higher matrix metallopeptidase 16 PMID: 27227700
- results suggest that miR-145 functions as a tumor metastasis suppressor gene by down-regulating MMP16 and may be a potential target in osteosarcoma treatment PMID: 26605780
- the results support a role for MMP16 in promoting invasive properties of the meningioma tumours PMID: 24989599
- These results demonstrate that the MT3-MMP promoter is frequently hypermethylated in colorectal cancer and that downregulation of MT3-MMP may be important for cell migration in colorectal cancer. PMID: 26002729
- MMP16 is a putative indicator of adverse melanoma prognosis. PMID: 25808867
- Expression of MMP-16 in HTB9 and T24 cells increases following transforming growth factorbeta1 treatment. PMID: 25017509
- E2F1 acts as a transcriptional activator for MMPs and directly enhances MMP transcription by binding to E2F1 binding sequences in the promoter, or indirectly activates MMPs (MMP-9 and MMP-16)through enhanced Sp1 and NF-kappa B PMID: 24755270
- Matrix metalloproteinase 16 (MMP16) was a downstream target of miR-146b-5p. PMID: 21823013
- The overexpression of miR-146b-5p in glioblastoma cell lines led to MMP16 mRNA silencing, MMP2 inactivation, and the inhibition of tumour cell migration and invasion. PMID: 23796692
- Data show that MMP16 is regulated by miR-146a in spontaneously differentiated Caco-2 cells. PMID: 22348245
- MT3-MMP is a matrix-dependent modifier of the invasive tumor cell functions during melanoma progression PMID: 22164270
- Results report the structure of the catalytic domain (cd) of the membrane-type matrix metalloproteinase MT3-MMP/MMP-16 in complex with the hydroxamic acid inhibitor batimastat. PMID: 14741217
- MT3-MMP is not only important in matrix degradation but also may affect the function of focal adhesions through FAK cleavage. PMID: 15044209
- Type-3 metalloproteinases, are identified as the triggering agents that independently confer cancer cells with the ability to proteolytically efface the BM scaffolding, initiate the assembly of invasive pseudopodia, and propagate transmigration. PMID: 16983145
- Chondroitin-4-sulfate, which is expressed on tumour cell surface, can function to bind to pro-MMP-2 and facilitate its activation by MT3-MMP-expressing tumour cells to enhance invasion and metastasis PMID: 17217338
- We have demonstrated the expression of MT3-MMP in hepatocellular carcinoma tissues (HCC) and that the expression in HCC significantly correlates with capsular invasion. PMID: 17419254
- MMP16 polymorphisms appear to influence not only the pulmonary expression and function of MMP16 but also the risk of bronchopulmonary dysplasia PMID: 18784838
- miR-146b is involved in glioma cell migration and invasion by targeting MMP16; implicating miR-146b as a metastasis-inhibiting miRNA in glioma PMID: 19265686
顯示更多
收起更多
-
亞細(xì)胞定位:[Isoform Long]: Cell membrane; Single-pass type I membrane protein; Extracellular side. Note=Localized at the cell surface of melanoma cells.; [Isoform Short]: Secreted, extracellular space, extracellular matrix. Cell surface. Note=Localized at the cell surface of melanoma cells.
-
蛋白家族:Peptidase M10A family
-
組織特異性:Expressed in heart, brain, placenta, ovary and small intestine. Isoform Short is found in the ovary.
-
數(shù)據(jù)庫鏈接:
Most popular with customers
-
YWHAB Recombinant Monoclonal Antibody
Applications: ELISA, WB, IHC, IF, FC
Species Reactivity: Human, Mouse, Rat
-
Phospho-YAP1 (S127) Recombinant Monoclonal Antibody
Applications: ELISA, WB, IHC
Species Reactivity: Human
-
-
-
-
-
-